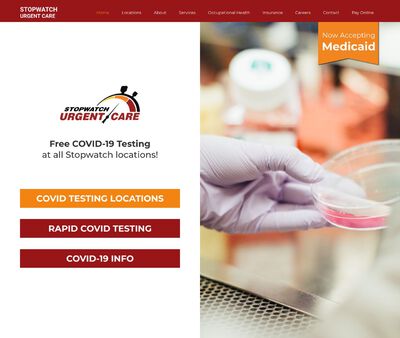

Preferred Location: 2000 10th Ave Columbus,GA 31901 Columbus Change location
Preferred Location: 2000 10th Ave Columbus,GA 31901 Columbus Change location

Phenix City has been recording rising rates of infectious diseases, notably sexually transmitted infections. In conjunction with the Alabama Rural Health Association, the Alabama Department of Public Health released a report on Russell County’s STD prevalence rates in 2013.
According to the report, there were 695 new incidences of sexually transmitted diseases between January 2012 and March 2013. The figure represents an STD prevalence rate of 127.4 per 100,000 individuals.
Also, the survey indicated that there were 31 new cases of HIV infection from 2009 through 2011. The disease had a rate of 19.5 cases per 100,000 population, as compared to Alabama’s infection rate of 14.6.
The state’s Public Health Division of HIV/AIDS Prevention and Care works closely with other community centers to control HIV rates, provide education, and promote healthy behavior among community members. Located in Montgomery, clients may also receive referrals to other clinics where they may receive HIV testing and treatment.
You can visit the Russel County Health Department located on W Luray St. Here, you may receive a wide range of STD care, including testing, prevention, and treatment, as well as case management services.
Otherwise, you may visit other nationwide providers for testing services — the Planned Parenthood clinic along 27th Place South. Clients may get a wide range of STD services, including testing, treatments, and immunization.
You may also find other health clinics that may deliver free STD testing and treatment. The disadvantage is that it may not have the prescribed drugs in case the results are positive. Also, the opening hours may be inconvenient.

The Centers for Disease Control and Prevention1 (CDC) recommends screening for the most common STDs, including chlamydia, gonorrhea, hepatitis B, hepatitis C, syphilis, herpes 1, herpes 2, and HIV for both men and women. In addition, the CDC suggests women get screened for trichomoniasis.
SaferSTD recommends searching for locations that offer a 10-test panel which tests for the most common bacteria and viral STDs in the U.S. with additional premium add-ons like early HIV detection, if needed.
The CDC2 provides detailed STD testing information as to when you should get tested. In summary, you should get tested today if you are sexually active, never been tested before, have had unprotected sex in the past, or if you exhibit symptoms.
According to the World Health Organization3, the majority of STI cases reported every day, more than one million, are asymptomatic; another reason to get tested today.
You should get tested again in 90 days to rule out STDs that have specific exposure waiting times, including HIV.
STD testing can be a quick and simple process, depending on the type of test you choose and where you get tested. Some may require an oral or genital swab, a urine test or blood sample, or a physical exam to check your genital area for signs of an STD.
SaferSTD has identified preferred providers that require only a urine test, a blood sample, or both without a physical exam.
The speed at which you receive your STD testing results depends on where you get tested. Before you choose your location, find out how long testing results will take.
At-home STD testing results are usually 3-5 business days, depending on the manufacturer of your test. You also need to take into account the amount of time it takes to receive the test or pick one up, perform the test, and ship it back, before the lab can analyze your results and report back to you.
If you test at a public facility such as a neighborhood clinic, you may have to wait a week, if not more for the results, which could delay treatment. If you test through a private facility, they have the fastest turnaround within 1-3 business days.
SaferSTD has researched and identified the most accredited and most reputable testing locations. Click here to find a preferred location near you.
Some STD testing clinics offer same-day walk-in options without an appointment. Below are nearby preferred locations that offer this option.
The cost of STD testing depends on whether you select private, public, or at-home testing, as well as the type of test(s) you need.
Several at-home STD options and public testing locations can cost up to $250, with most on the higher end, depending on the brand and type of testing. Public testing fees also vary based on income and welfare eligibility.
With private testing, you may save money on a low-cost comprehensive 10-test panel that tests for the most common bacterial and viral STDs in the United States.
SaferSTD has researched and identified reputable locations that offer upfront pricing without hidden fees. Click here to find a preferred location near you.

JPL Family and Pediatric Medicine is a health clinic that offers quality health-care services to the residents of Phenix City, AL, and the Tri-City area. It has physicians who are competent in administering vaccines, pediatric care, and screening for diabetes as well as management of cancer and allergies. Clients may also seek STD evaluation services.
Planned Parenthood - East Atlanta Health Center of Atlanta, GA, is a medical clinic that offers standard reproductive health-care services to the residents of Atlanta, GA, and surrounding areas. Some services patients may receive include family planning, abortion care, vasectomy, and STD screening and treatment. To conduct an HIV test, a clinician may utilize finger sticks and avail results in about 10 to 40 minutes.
Russell County Health Department is a public medical facility that offers equitable health-care services to the residents of Phenix City, AL. It possesses a staff that’s competent in providing services such as prostate cancer screening, vaccinations, tuberculosis treatment, management of chronic conditions, and pediatric care. Also, you may receive STD testing and treatment services.
Columbus Health Department is a medical facility that offers disease preventative services intending to improve the quality of health of communities living in and around Columbus, GA. Its compassionate physicians are well-trained in offering health-care services such as diabetes management, immunizations, birth control, and dental health and pediatric care. Medical practitioners may also proffer STD screening and treatment services.
Stopwatch Urgent Care is a health center that offers all-inclusive health-care services to the residents of Phenix City, AL, and nearby areas. It’s staffed with physicians who are experienced in offering services such as immunizations and treatment of lacerations, minor injuries, gout, and upper respiratory infections. Patients seeking STD screening services may also receive medical care.
American Family Care is a collection of urgent care clinics, and it has been operational since 1982, offering standard health-care services to people living all over the US. Its Columbus, GA, clinic has doctors who are adroit in offering accurate STD evaluation services. Additionally, clients may receive other services, including vaccinations, treatment of illnesses, sports physicals, and drug screening.


Call our Expert Care Advisors at


Accredited and Certified
These location types are best for: Privacy and convenience
Description: Order online and receive a doctor's order to visit this lab to get tested in as little as 15 mins. Get your results privately within 1-2 business days and speak with a doctor over the phone if your test results come back positive. Doctors may prescribe treatment or refer you to a specialist if needed.
Accredited and Certified
These location types are best for: Privacy and convenience
Description: Getting an STD test at a clinic near you has never been easier. When you choose this location, you can get a doctor's requisition to get tested in as little as 15 minutes. Following your test, you receive your results privately within 2 business days, and can speak to a doctor over the phone with confidence, should results come back as positive.
Accredited and Certified
These location types are best for: Privacy and convenience
Description: Why go to a public clinic? Get convenient and fast STD testing that is 100% confidential. Individual tests under $50. Order online and visit this lab the same day for a quick 15 min test. Get your results online within 1-2 business days, and view them privately. Doctor consultation available over the phone, should results come back as positive.
Accredited and Certified
These location types are best for: Privacy and convenience
Description: Get Fast, Easy and Affordable testing at this location. Results come back within 2 business days and be in and out of the lab in less then 20 minutes.
Show only locations where privacy and discretion is taken into importance.
Description: Public Health Department/Social Services Department. Please call for HIV testing hours
Description: Community Based Organization. Also available for testing at Community Health Fairs, Civic Events, etc., call 706-596-5517 to schedule
Show only locations where you can easily book your test online.
Description: Public Health Department/Social Services Department. STD Clinic provided for Muscogee County Residents. Will accept Alabama and Ft. Benning residents (100% pay required). HIV Testing is available without an appointment. Hours are 8:30am-4pm, Mon.-Fri. For questions, please call 706-321-6413
Description: Need to enroll as a patient in order to access services.
Description: Public Health Department/Social Services Department. Closed 12pm-12:30pm for lunch
Show only locations where they offer the HIV RNA Early Detection Test for people who think they may have been recently exposed to the HIV virus
Description: Public Health Department/Social Services Department. Closed at 12noon-1pm for lunch
You may receive inexpensive STD tests if you visit the health center since there are no restrictions on service provision. Additionally, physicians may bill some insurances, and if you are a self-pay patient, the staff may accept credit cards and check payments.
You may receive STD services through scheduling an appointment or walking into the clinic, depending on the option you prefer. Additionally, physicians conduct quick and accurate STD tests and release results to patients in-person. If you visit the clinic, physicians assure you of confidential STD services.
1810 Stadium Dr #210, Phenix City, AL 36867, USA

Clinicians offer low-cost STD testing to everyone in need of the services, and uninsured clients may foot bills using cash or credit cards, all at a discounted rate. Also, the medical team accepts some public and private insurances, and clients who are unable to pay bills may qualify for a state-funded program.
The clinic has an online platform that operates 24 hours a day, so clients may schedule an appointment anytime. Also, the medical team offers services in English, but you may notify a staff member if you need translation services to other languages. Moreover, you’re bound to receive discreet medical care at the health center.
440 Moreland Ave SE, Atlanta, GA 30316, USA

Health-care providers offer STD testing and treatment at zero costs to everyone living in and around Russell County.
Physicians offer extensive and standard STD services, free of charge. Additionally, if you need medical care, you may reserve an appointment through a phone call. Moreover, clinicians are proficient in delivering STD services with confidentiality.
1850 Crawford Rd, Phenix City, AL 36867, USA

Health-care providers offer STD services at sliding scale rates to everyone, and if you're uninsured, physicians may accept cash, credit cards, and debit cards as payment modes. Also, medical practitioners may bill various insurances, including Medicare and Medicaid.
With the aid of the Ryan White funds, HIV positive clients may receive low-priced or free medication. Also, medical practitioners offer confidential partner notification services. Moreover, clients may receive STD services that are accurate and discreet, and you may schedule an appointment via phone call to see a doctor.
2100 Comer Ave, Columbus, GA 31904, USA

Physicians offer STD services to everyone at a low price, and if you’re uninsured, you may make online payments using credit cards. Also, health-care providers may bill some major insurance health plans to clear the medical fees of insured clients.
Patients with a tight work-day schedule may receive STD services for extended hours, and services are available seven days a week. Also, clients may get discreet STD evaluation services. You may book an appointment to receive STD services.
5415 Summerville Rd b, Phenix City, AL 36867, USA
Anyone may receive low-priced STD services and settle bills online using credit cards or debit cards, and if you’re insured, a health-care provider may bill your insurance provider.
Clients with compact daytime and weekday schedules may get STD services on the weekends or evenings since the clinic is open for extended hours, seven days a week. Also, your health-care provider may offer you the services you need comprehensively and with discretion. Moreover, you may walk into the clinic at a suitable time that fits into your schedule.
6509 Gateway Rd, Columbus, GA 31909, USA

Each page below contains a detailed report of the local area, location STD statistics and clinic reviews of some the top STD testing locations. The content is curated by our very own editors and medical experts.






